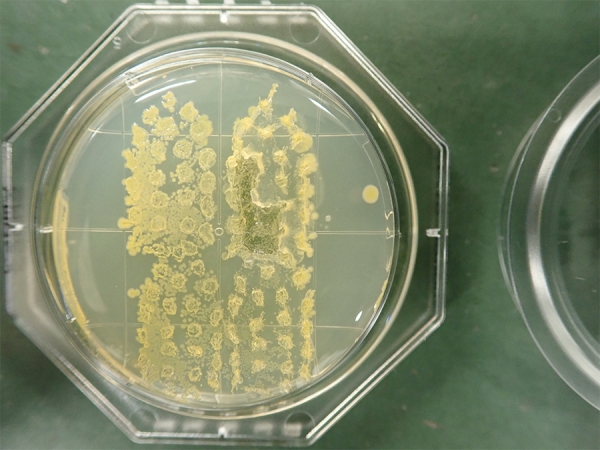

お金に汚い人とは (390 無料画像)
美女の本音は「歯が汚い人と肌が汚い人、どっちが嫌って歯が汚い人!」ボディメンテLEON レオン オフィシャルWebサイト。
稼げない人の思い込み お金は汚いものドラゴン先生。
お金は汚いもの」は日本人の美徳? 金融教育を150年遅らせた戦国武将の正体お金のむこうに人がいるダイヤモンド・オンライン。
トイレが汚い人は危ない!破産する人、6つのタイプ « 女子SPA。
義母の金銭要求>義父の遺産で豪遊!SNSから金遣いの荒さが発覚「お金に汚い人」 中編まんがママスタセレクト。
お金は「汚い」「悪い」もの? 日本人が刷り込まれてきた負のイメージいま君に伝えたいお金の話村上世彰 - 幻冬舎plus。
お金が貯まる人は、なぜ部屋がきれいなのか 「自然に貯まる人」がやっている50の行動黒田 尚子 本通販Amazon。
汚い」って何だ!? お金・スマホ・トイレ 身のまわりの菌を採取して免疫学の先生に聞いてみたKindai Picks。
義母の金銭要求>義父の遺産で豪遊!SNSから金遣いの荒さが発覚「お金に汚い人」 中編まんがママスタセレクト。
お金はね、ありがたいと思って使ってごらん。喜びながら使うと、世界は豊かになるんだ。お金はよく悪者扱いされるけど、汚い ものでもなければ、ズルいものでもないんだよ。お金とは、人も国も、そして世界も幸せにすることができる『愛』そのものです。 ひとり 斎藤一人。
お金持ちでトイレが汚い人はいない!? 読めば、あなたも掃除がしたくなる!好きになる! 風水で運気を変えよう不妊治療・妊活のクリニック探し・情報収集ならあかほし 赤ちゃんが欲しい。
家が汚い人はお金も滞る!?家とお金のカンケイについて家族の運が動き出す!奇跡の☆家の氣の整えかた。
日本人はお金が大好き!」お金をタブー視する人たちのホンネ 三田紀房×藤野英人対談 後編ジセダイ。
お金に愛されない人の特徴 ~知るだけで豊かになれる! お金のコミュニケーション 基礎・必須編- YouTube。
お金のメンタルブロックを解除します!潜在意識・両親の影響・金銭感覚原田 靖子。
貧乏になる人の特徴を知ってる それは中学生から新聞配達をするくらい貧乏だったから身近で見てきたから "お金の話をするのは汚いこと" "お金持ちは悪""現状を見て見ぬフリをする" こんなふうに思っているとお金は逃げていく 貧乏な環境から脱出したくて 自分と向き合っ。
お金持ちになりたくない人は ・お金は汚い ・お金は品がない ・お金は諸悪の根源だ そんな風に思っているねんな。 でもお金は中立や。 お金自体が不幸を呼ぶもんとちゃうで。ワシとしては、みんなにお金持ちになって欲しいと思ってる^^ ・良い稼ぎ方をして ・良い使い方。
汚い服を着た人は、チャンスを逃す。着られれば何でもいいという発想は思考停止だ新R25 Media - シゴトも人生も、もっと楽しもう。
マンガで学ぶ 「お金は汚い」日本人の洗脳を解除せよ!元日経新聞記者が力説する理由インベスターZで学ぶ経済教室ダイヤモンド・オンライン。
お金だけじゃない」という人ほどお金に汚い?ニューリッチへの道All About。
雑学&豆知識 お金に汚い人の特徴 人間関係- YouTube。
お金は汚いもの」は日本人の美徳? 金融教育を150年遅らせた戦国武将の正体お金のむこうに人がいるダイヤモンド・オンライン。
お金は汚いもの」は日本人の美徳? 金融教育を150年遅らせた戦国武将の正体お金のむこうに人がいるダイヤモンド・オンライン。
マンガで学ぶ 「お金は汚い」日本人の洗脳を解除せよ!元日経新聞記者が力説する理由インベスターZで学ぶ経済教室ダイヤモンド・オンライン。
義母の金銭要求>義父の遺産で豪遊!SNSから金遣いの荒さが発覚「お金に汚い人」 中編まんがママスタセレクト。
お金に執着する人の末路 スピリチュアルな法則金に汚い人は縁もカネも離れていくリアル。
金運がない人の共通点 お金が貯まらない家の特徴4つInfoseekニュース。
漫画 大人は汚い!優しい人だと思っていたのに 保険金を貸してほしいだなんて 16歳で帰らなくなった弟Fandomplus ファンダムプラス。
マンガで学ぶ 「お金は汚い」日本人の洗脳を解除せよ!元日経新聞記者が力説する理由インベスターZで学ぶ経済教室ダイヤモンド・オンライン。
お金に汚い人の特徴10個と付き合い方・末路 - Trairy Media。
成功者の心得 「お金を悪く言う人」とは付き合うな! 悪代官とダブる姿 - ZAKZAK。
マンガで学ぶ 「お金は汚い」日本人の洗脳を解除せよ!元日経新聞記者が力説する理由インベスターZで学ぶ経済教室ダイヤモンド・オンライン。
全部、娘に任せたい」暴走する父から母を守るため、専門窓口へ相談に行くも母の ベビーカレンダ。
義母の金銭要求>義父の遺産で豪遊!SNSから金遣いの荒さが発覚「お金に汚い人」 中編まんがママスタセレクト - Part 3。
お金は汚いものと考える人はヤバイ。お金の在り方について考える - 2児パパの裏ブログ。
一生お金に困らない生き方心屋 仁之助 本通販Amazon。
部屋が汚い人は年収が低い!お金持ちから学べる、金運をあげるちょっとした習慣とは?持たない暮らし、使い切る暮らし。
お金は「汚い」「悪い」もの? 日本人が刷り込まれてきた負のイメージいま君に伝えたいお金の話村上世彰 - 幻冬舎plus。
とし AI才能鑑定 素質 能力 強み on X: "9割の人は 知らないけど、『引き寄せの法則』が凄すぎます。「想いの通じない人間関係」「カツカツで回しているお金 」「やりがいを感じない仕事」実はコレ、無意識にある「自分は愛されない」「お金は汚いもんだ」「仕事は生活費。
お金は汚いもの」は日本人の美徳? 金融教育を150年遅らせた戦国武将の正体お金のむこうに人がいるダイヤモンド・オンライン。